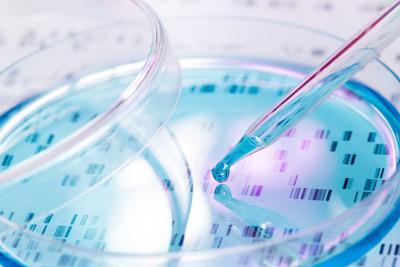
Advancing Patient-Derived Stem Cell Research

Omar Aziz
Scientific Business Director

Omar Aziz is the Scientific Business Director for Charles River Discovery, focusing on the advanced modalities portfolio. With over 20 years of drug discovery experience across multiple therapeutic areas and modalities, Omar supports the Discovery strategy for advanced modalities within Charles River and the strategic decision making for projects at individual or multiple Discovery sites to deliver optimal therapeutics for safety testing and beyond.
Omar joined Charles River following the acquisition of the BioFocus and Argenta Discovery sites in April 2014. Prior to this he was a research scientist at both Pfizer UK Ltd and also at Lectus Therapeutics, a small biotech company, managing projects across multiple therapeutic areas.
Omar received his Ph.D. from the University of Newcastle-upon-Tyne in 2001 and followed this with three years of postdoctoral training in the USA at the NIEHS, Research Triangle Park, North Carolina before starting a career in drug discovery at Pfizer, UK and then at Lectus Therapeutics UK.